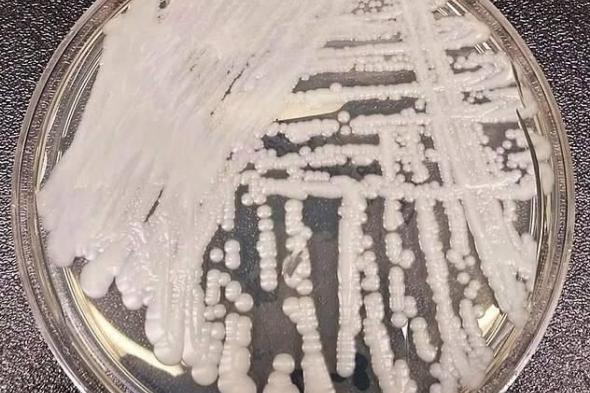
فطر
قاتل
مقاوم
للعلاج
ينتشر
في
مستشفيات
أمريكية

منوعات00

أعلنت وزارة الزراعة واستصلاح الأراضي في مصر وصول الموالح ...
المزيد ...
منوعات00
تشهد مستشفيات أمريكية انتشاراً سريعاً لفطر كانديدا أوريس القاتل ...
المزيد ...
منوعات00

نجا 4 رجال من موت محقق بنهر فال في ...
المزيد ...
الامارات00

مشاركات خارجية وتوجه برلماني نوعي مع روسيا وأرمينيا الحرص ...
المزيد ...
الامارات00

أبوظبي - وام وجه صاحب السمو الشيخ محمد بن ...
المزيد ...
اقتصاد00

الصناديق الإماراتية/ درهم «أديا» السابع عالمياً بـ 4.33 تريليون ...
المزيد ...
اقتصاد00

أعلنت سوق دبي الحرة أن مبيعاتها السنوية سجلت أرقاماً ...
المزيد ...
رياضة00

تختتم، الخميس، مواجهات الجولة التاسعة من دوري نجوم العراق ...
المزيد ...
رياضة00

رفضت الهيئة الإدارية لنادي الزوراء الرياضي العراقي، التفريط بخدمات ...
المزيد ...
منوعات00

كشفت شركة استوديوهات «والت ديزني» للرسوم المتحركة، الأربعاء، أن ...
المزيد ...
اقتصاد00

قال إيلون ماسك في منشور على منصة إكس: إن ...
المزيد ...
الامارات00

أعلنت القيادة العامة لشرطة الشارقة نجاح خطتها الأمنية الشاملة ...
المزيد ...